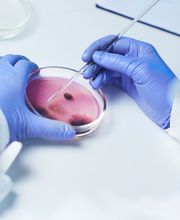
Gallery Cliente

Chiama ora!
Casa di Cura Privata Santa Teresa
Centro medico · Ricerca
0.0(0 Recensione)
Via Nazionale, 7/25, 03036 Isola del Liri
Novità e Offerte
Info
Lo staff della Casa di Cura privata Santa Teresa altamente qualificato e composto da medici di grande spessore, sarà lieto di poter assistere i pazienti, essendo accreditata con il SSR per ortopedia e traumatologia, chirurgia, cardiologia, diagnostica per immagini, analisi chimico cliniche. Da oltre 60 anni la Casa di Cura è al servizio dei suoi clienti con professionalità e serietà, offrendo la possibilità di visite, servizi diagnostici e terapeutici, in molteplici branche sia mediche che chirurgiche.
Galleria

Mappa
Via Nazionale, 7/25, 03036 Isola del Liri
Recensione
Recensioni non verificate0.0
(0 Recensione)